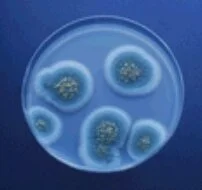

Alpine Environmental Services is a leading provider of environmental consulting, testing and mitigation services in upstate New York. Our staff of engineers, industrial hygienists, environmental scientists, inspectors, and sampling technicians allow ALPINE to provide all phases of an environmental project, from inspection and design to monitoring and mitigation. Our strength is in our experienced staff and our ability to provide quality field services on large projects operating twenty-four hours a day, seven days a week. Our approach is based on providing cost effective solutions to environmental issues with an eye fixed on the real world concerns of risk management and project budgets.
Design
Our engineers have broad design experience from asbestos /lead/PCB/mold abatement project design, to soil and groundwater remedial project design, to industrial ventilation and vapor/gas mitigation system design. ALPINE has New York State Licensed Professional Engineers on staff.
Testing
Our widely certified testing staff has decades of experience in compliance testing for asbestos and lead projects, in house design of testing plans and execution (i.e. vapor intrusion investigation testing, post mitigation mold testing, etc.) and less conventional testing such as sewer vent leak smoke testing and slab water vapor infiltration testing. Other standard testing includes industrial hygiene exposure monitoring, indoor air quality testing, and LEEDS testing. ALPINE has a Certified Industrial Hygienist (ABIH) on staff and a NYS DOH ELAP Certified Laboratory for Asbestos Air Sample Analysis.
Inspection
ALPINE's certified inspection staff is cross-trained to handle multi facets of environmental inspection. For a small asbestos and lead-based paint inspection, we only need to send one inspector who has certifications in both asbestos and lead paint inspections. This cost savings can be passed on to the client.
Mitigation
ALPINE is a leader in the design and installation of Vapor / Gas intrusion Mitigation Systems. Our experience ranges from the very common radon, gasoline, fuel oil, benzene, and chlorinated solvent (i.e. perk, TCE. etc.) mitigation to the much less common methane mitigation (unrelated to landfill). Our design staff has collected a "toolbox" of proven system components to address almost any vapor intrusion / gas mitigation problem.
Phone (518)250-4047
We look forward to working closely with you to address your environmental testing, design, and mitigation needs.
Phone (518)250-4047